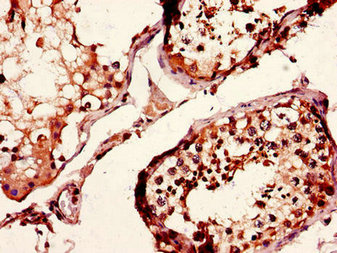

CD37 Antibody
-
中文名稱:CD37兔多克隆抗體
-
貨號:CSB-PA004928LA01HU
-
規格:¥440
-
圖片:
-
Western Blot
Positive WB detected in: Mouse liver tissue, Mouse brain tissue
All lanes: CD37 antibody at 2.7μg/ml
Secondary
Goat polyclonal to rabbit IgG at 1/50000 dilution
Predicted band size: 32, 24, 23 kDa
Observed band size: 32 kDa -
Immunohistochemistry of paraffin-embedded human testis tissue using CSB-PA004928LA01HU at dilution of 1:100
-
Immunofluorescent analysis of Hela cells using CSB-PA004928LA01HU at dilution of 1:100 and Alexa Fluor 488-congugated AffiniPure Goat Anti-Rabbit IgG(H+L)
-
-
其他:
產品詳情
-
產品名稱:Rabbit anti-Homo sapiens (Human) CD37 Polyclonal antibody
-
Uniprot No.:
-
基因名:
-
別名:CD37; TSPAN26; Leukocyte antigen CD37; Tetraspanin-26; Tspan-26; CD antigen CD37
-
宿主:Rabbit
-
反應種屬:Human, Mouse
-
免疫原:Recombinant Human Leukocyte antigen CD37 protein (109-237AA)
-
免疫原種屬:Homo sapiens (Human)
-
標記方式:Non-conjugated
本頁面中的產品,CD37 Antibody (CSB-PA004928LA01HU),的標記方式是Non-conjugated。對于CD37 Antibody,我們還提供其他標記。見下表:
-
克隆類型:Polyclonal
-
抗體亞型:IgG
-
純化方式:>95%, Protein G purified
-
濃度:It differs from different batches. Please contact us to confirm it.
-
保存緩沖液:Preservative: 0.03% Proclin 300
Constituents: 50% Glycerol, 0.01M PBS, PH 7.4 -
產品提供形式:Liquid
-
應用范圍:ELISA, WB, IHC, IF
-
推薦稀釋比:
Application Recommended Dilution WB 1:1000-1:5000 IHC 1:20-1:200 IF 1:50-1:200 -
Protocols:
-
儲存條件:Upon receipt, store at -20°C or -80°C. Avoid repeated freeze.
-
貨期:Basically, we can dispatch the products out in 1-3 working days after receiving your orders. Delivery time maybe differs from different purchasing way or location, please kindly consult your local distributors for specific delivery time.
-
用途:For Research Use Only. Not for use in diagnostic or therapeutic procedures.
相關產品
靶點詳情
-
基因功能參考文獻:
- CD37 is a critical determinant of rituximab plus cyclophosphamide, doxorubicin, vincristine, and prednisone outcome in diffuse large B-cell lymphoma. PMID: 27760757
- Data indicate that cell differentiation antigen 37 (CD37) is well expressed and a potential drug target in acute myeloid leukemia (AML). PMID: 25934707
- The CD37-targeted antibody-drug conjugate IMGN529 is highly active against human CLL and in a novel CD37 transgenic murine leukemia model. PMID: 24445867
- Data indicate that enhanced antibody-dependent cell cytotoxicity (ADCC) is observed against chronic lymphocytic leukemia cells and is sustained at concentrations of SMIP-016(GV) as low at 5E(-6) microg/mL on cells expressing minimal CD37 antigen. PMID: 23883821
- Identify two tyrosine residues in tetraspanin CD37 directly mediating transduction of survival and apoptotic signals. PMID: 22624718
- In the absence of both CD37 and Tssc6, immune function is further altered when compared with CD37- or Tssc6-deficient transgenic mice, demonstrating a complementary role for these two molecules in cellular immunity. PMID: 20709950
- CD37 cross-linking on human T cells transduces signals that lead to complete inhibition of CD3-induced T cell proliferation. PMID: 14978098
- CD37 is important for dectin-1 stabilization in APC membranes and controls dectin-1-mediated IL-6 production. PMID: 17182550
- provide strong justification for CD37 as a therapeutic target and introduce small modular immunopharmaceuticals as a novel class of targeted therapies for B-cell malignancies PMID: 17440052
顯示更多
收起更多
-
亞細胞定位:Membrane; Multi-pass membrane protein.
-
蛋白家族:Tetraspanin (TM4SF) family
-
組織特異性:B-lymphocytes.
-
數據庫鏈接:
Most popular with customers
-
-
YWHAB Recombinant Monoclonal Antibody
Applications: ELISA, WB, IHC, IF, FC
Species Reactivity: Human, Mouse, Rat
-
Phospho-YAP1 (S127) Recombinant Monoclonal Antibody
Applications: ELISA, WB, IHC
Species Reactivity: Human
-
-
-
-
-